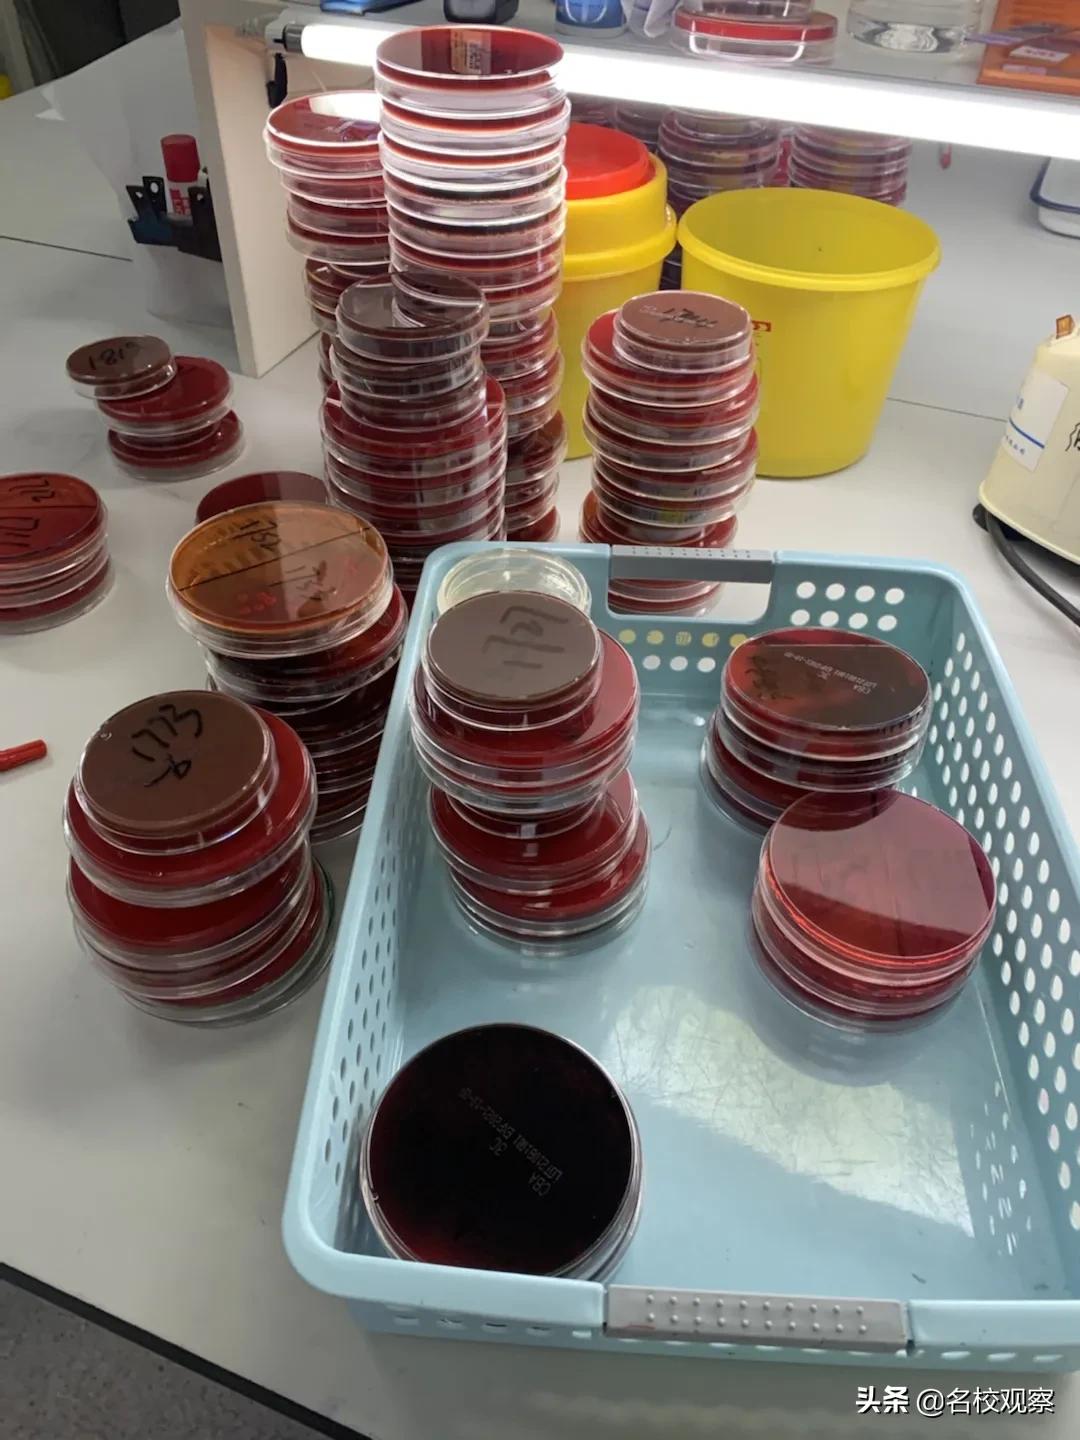
当医学生是什么样的感受,当一名医生的感受

金苹果锦城一中初2019级学生职业体验汇报系列报道四
大家好,我是来自金苹果锦城一中2019级四班的王梓彤。出于平日对生物、医学的喜爱,在这次活动中,我选择体验的职业是“医学检验师”。那么这是一份什么样的职业呢?

简单来说,在医院中,患者将血液、尿液等体液的标本送到检验科,而医学检验师则负责检测体液成分,出具检验报告,为医生的诊断提供科学依据。这看似简单的工作背后却蕴藏着不简单。今天,就让我们一起走进“医学检验师”的职业世界吧!
壹
行前职业调查
在开始职业体验之前,我先了解了检验科的组成,检验科主要分为四个主要片区:临床检验、免疫、微生物和分子(pcr)实验室。

临床检验主要负责血液的一般检验;
免疫主要负责为患者提供体液免疫学、细胞免疫学等检验;
微生物主要负责对传染病疫情、突发事件相关的微生物和寄生虫等检验、病原学鉴定;
分子(pcr)实验室又叫基因扩增实验室。主要负责通过分子生物学技术放大特定的DN*片A**段,可看作复制生物体外的特殊DNA。
新冠疫情爆发以来,全国医疗机构和疾控机构迅速落实国家有关要求,开展新冠病毒核酸检测工作,而医学检验师在疫情防控中则发挥了至关重要的作用。
在访谈了几位医学检验师后,我了解到一名合格的医学检验师所需具备的职业素质。在医科大学中,医学检验专业已经归到了临床检验这一系别。如果想要在一家三甲医院担任医学检验师,你需要具备硕士及以上的学历、大学英语六级、职业资格证书等,以及各种职业能力,如专业技术能力、良好的书写能力、口头表达能力、分析问题和解决问题的能力等。
贰
职业体验
职业体验的第一天,我熟悉了实验室生物安全防护流程,包括正确洗手、穿脱防护服等,在临检实验室认识了血液涂片和骨髓涂片的细胞,学习了调配凝血试剂的操作流程,最后还参与了胸腹水的比重检测工作。

第二天,我来到了微生物实验室。

同学们知道这是什么吗?这是一种帮助细菌、真菌生长的血液平板。医学检验师们将无法完全确定的真菌放在血液平板上让他们自由生长。我在这里初步认识了异常真菌的鉴定方式。
第三天,我跟随医学检验师揭开了这些细菌、真菌的神秘面纱。在先进医学仪器的帮助下,我们可以通过颜色、外观等特征精准地判断出细菌、真菌的种类。


叁
收获与感悟
虽然职业体验只有短短三天,但我仍然强烈地感受到医学工作者的不易与责任。在异常繁重的工作量下,医学检验师需要高效率、高质量地出具每一份检测报告,这对医生的专业能力、耐心、细心和毅力都是巨大的挑战。

在整个职业体验过程中,我学会了换位思考,对于医生这个职业有了更多的理解,对于医学、医患关系有了更多的思考。医学是在探索中发展的,医生也不是无所不能的。在新冠疫情常态化防控的背景下,我对医生,特别是医学检验师更加充满敬意。希望通过我的职业体验汇报,能让同学们更加了解医生、理解医生、相信医生,一起构建和谐的医患关系。
班内部分同学分享图片


